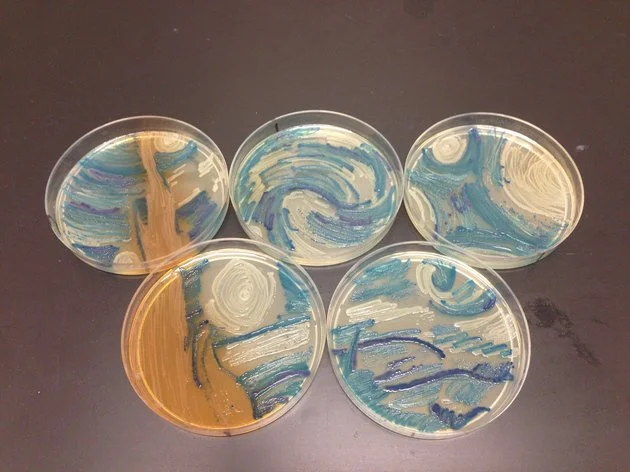

Primo classificato: Mehmet Berkmen e Maria Penil, "Neuroni" composto di Nesterenkonia, Deinococcus e Sphingomonas.
C’era una riproduzione della famosa “Notte Stellata” di Van Gogh, un paesaggio, fiori, un susseguirsi di volti che ricorda vagamente Warhol ma anche altri lavori di registro più basso, giocati sull’illustrazione e il fumetto. C’era persino una mappa di New York. Che c’è di strano? Niente, non fosse che gli autori hanno usato i vetrini invece delle tele e i batteri al posto dei colori.
La competizione indetta dalla American Society for Microbiology's si intitola Agar Art e dall’anno scorso si propone di diventare un appuntamento fisso.
Mostrando la bellezza nascosta nei temibili microrganismi. Se riusciranno non è dato sapere, di certo però, c’è che tutti i biologi in gara hanno fatto del loro meglio. Tanto che l’Asm nella pagina Facebook dedicata alla curiosa manifestazione, dice che è stato molto difficile scegliere un vincitore per l’edizione 2015 (via Huffington Post edizione Usa).
Non premiato: Melanie Sullivan ,"Notte Stellata" , batteri vari in Capsula di Petri
Secondo calssificato: Autori vari, “NYC Biome Map,” multiplo di capsule di Petri di batteri modificati sotto luce UV con proteine fluorescenti.
Terzo classificato: Maria Eugenia Inda, “La stagione del raccolto,” composto di lievito Saccharomyces cerevisiae.
Scelto dal Pubblico: Maria Penil, “Cellula a Cellula,” composto di Seinococcus e batteri Sphingomonas.